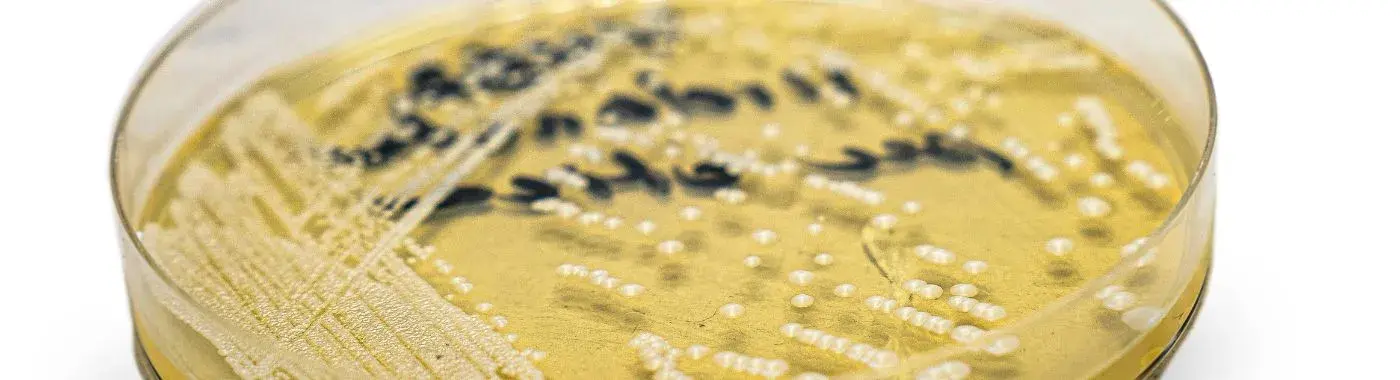
Candida Parapsilosis - Causes, Symptoms, Diagnosis, Treatment, and Prevention

- Diseases and Conditions
- Candida Parapsilosis - Causes, Symptoms, Diagnosis, Treatment, and Prevention
Candida Parapsilosis - Causes, Symptoms, Diagnosis, Treatment, and Prevention
Understanding Candida Parapsilosis: A Comprehensive Guide
Introduction
Candida parapsilosis is a type of yeast that is part of the normal flora of the human body, particularly found on the skin and mucous membranes. While it is typically harmless in healthy individuals, it can become pathogenic, leading to infections, especially in immunocompromised patients. Understanding Candida parapsilosis is crucial for both healthcare professionals and the general public, as it can have significant implications for health, particularly in hospital settings where vulnerable populations are present.
Definition
What is Candida Parapsilosis?
Candida parapsilosis is a species of yeast belonging to the Candida genus. It is a dimorphic fungus, meaning it can exist in both yeast and filamentous forms. This organism is commonly found in the environment, including soil and water, and is also part of the normal microbiota of humans. While it is not the most common Candida species associated with infections, it has gained attention due to its increasing prevalence in clinical settings, particularly among patients with weakened immune systems.
Causes and Risk Factors
Infectious/Environmental Causes
Candida parapsilosis can be found in various environments, including hospitals, where it can be transmitted through contaminated surfaces or medical equipment. It can also be introduced into the body through invasive procedures, such as catheter insertions or surgeries. The yeast thrives in warm, moist environments, making certain hospital settings ideal for its growth.
Genetic/Autoimmune Causes
While Candida parapsilosis infections are primarily opportunistic, certain genetic predispositions may increase susceptibility. Individuals with genetic disorders affecting immune function or those with autoimmune diseases may be at higher risk for developing infections caused by this yeast.
Lifestyle and Dietary Factors
Diet and lifestyle can influence the body's microbiome, including the balance of Candida species. Diets high in sugar and refined carbohydrates may promote the overgrowth of Candida, including Candida parapsilosis. Additionally, lifestyle factors such as stress, lack of sleep, and poor hygiene can contribute to an imbalance in the body's natural flora.
Key Risk Factors
- Age: Infants, particularly premature ones, and the elderly are at higher risk due to immature or weakened immune systems.
- Gender: While both genders can be affected, women may be more prone to yeast infections due to hormonal changes.
- Geographic Location: Certain regions may have higher incidences of Candida infections due to environmental factors.
- Underlying Conditions: Conditions such as diabetes, cancer, HIV/AIDS, and other immunocompromising conditions significantly increase the risk of infection.
- Invasive Procedures: Patients undergoing surgeries or those with indwelling catheters are at increased risk for Candida parapsilosis infections.
Symptoms
Common Symptoms
The symptoms of Candida parapsilosis infections can vary depending on the site of infection. Common symptoms include:
- Skin Infections: Redness, itching, and rash, often in warm, moist areas of the body.
- Nail Infections: Discoloration, thickening, and separation of the nail from the nail bed.
- Systemic Infections: Fever, chills, and malaise, particularly in immunocompromised individuals.
Warning Signs
Immediate medical attention should be sought if an individual experiences:
- Persistent fever that does not respond to treatment.
- Signs of sepsis, such as rapid heart rate, confusion, or difficulty breathing.
- Severe skin infections that do not improve with over-the-counter treatments.
Diagnosis
Clinical Evaluation
The diagnosis of Candida parapsilosis infections begins with a thorough clinical evaluation. Healthcare providers will take a detailed patient history, including any recent hospitalizations, surgeries, or underlying health conditions. A physical examination will help identify any visible signs of infection.
Diagnostic Tests
- Laboratory Tests: Blood cultures, tissue biopsies, or swabs from infected areas can be tested for the presence of Candida parapsilosis.
- Imaging Studies: In cases of suspected systemic infection, imaging studies such as X-rays or CT scans may be used to identify any internal complications.
- Specialized Procedures: Invasive procedures may be necessary to obtain samples from deep tissues or organs.
Differential Diagnosis
It is essential to differentiate Candida parapsilosis infections from other types of infections, such as bacterial or viral infections, as the treatment approaches may differ significantly. Conditions like bacterial skin infections, other fungal infections, and even autoimmune diseases may present with similar symptoms.
Treatment Options
Medical Treatments
- Antifungal Medications: The primary treatment for Candida parapsilosis infections involves antifungal medications, such as fluconazole or echinocandins. The choice of medication may depend on the severity of the infection and the patient's overall health.
- Surgical Options: In cases of severe infection, surgical intervention may be necessary to remove infected tissue or drain abscesses.
Non-Pharmacological Treatments
- Lifestyle Modifications: Maintaining good hygiene, managing blood sugar levels (for diabetics), and reducing stress can help prevent infections.
- Dietary Changes: A balanced diet low in sugar and refined carbohydrates may help maintain a healthy microbiome.
Special Considerations
- Pediatric Patients: Treatment in children may require careful dosing and monitoring due to their developing bodies.
- Geriatric Patients: Older adults may have different responses to antifungal treatments and may require adjustments based on their overall health status.
Complications
Potential Complications
If left untreated, Candida parapsilosis infections can lead to severe complications, including:
- Sepsis: A life-threatening response to infection that can lead to organ failure.
- Chronic Infections: Persistent infections that may require long-term treatment.
- Disseminated Infections: Spread of the infection to other parts of the body, including the bloodstream and internal organs.
Short-Term and Long-Term Complications
Short-term complications may include localized infections that can worsen if not treated promptly. Long-term complications can involve chronic health issues, particularly in immunocompromised individuals, leading to recurrent infections and prolonged treatment courses.
Prevention
Strategies for Prevention
- Hygiene Practices: Regular handwashing and maintaining clean environments can reduce the risk of infection.
- Dietary Modifications: A diet rich in probiotics and low in sugars can help maintain a healthy balance of microorganisms.
- Vaccinations: Staying up to date with vaccinations can help prevent infections that may predispose individuals to Candida infections.
- Lifestyle Changes: Managing stress, getting adequate sleep, and avoiding smoking can strengthen the immune system.
Prognosis & Long-Term Outlook
Typical Course of the Disease
The prognosis for Candida parapsilosis infections largely depends on the patient's overall health, the timeliness of diagnosis, and the effectiveness of treatment. Most healthy individuals can recover fully with appropriate treatment.
Factors Influencing Prognosis
Early diagnosis and adherence to treatment are critical for a favorable outcome. Patients with underlying health conditions may require more intensive management and monitoring.
Frequently Asked Questions (FAQs)
- What is Candida parapsilosis?
Candida parapsilosis is a type of yeast that can cause infections, particularly in immunocompromised individuals. It is part of the normal flora but can become pathogenic under certain conditions.
- What are the symptoms of a Candida parapsilosis infection?
Symptoms can include skin rashes, nail infections, and systemic symptoms like fever and chills, especially in those with weakened immune systems.
- How is Candida parapsilosis diagnosed?
Diagnosis involves clinical evaluation, laboratory tests, and sometimes imaging studies to confirm the presence of the yeast.
- What treatments are available for Candida parapsilosis infections?
Treatment typically includes antifungal medications and may involve surgical intervention in severe cases.
- Can lifestyle changes help prevent Candida parapsilosis infections?
Yes, maintaining good hygiene, a balanced diet, and managing stress can help reduce the risk of infections.
- Who is at risk for Candida parapsilosis infections?
Individuals with weakened immune systems, such as those with diabetes, cancer, or undergoing invasive procedures, are at higher risk.
- What complications can arise from untreated Candida parapsilosis infections?
Complications can include sepsis, chronic infections, and the spread of infection to other body parts.
- Is Candida parapsilosis contagious?
While it is not typically contagious, it can be transmitted in healthcare settings, particularly among vulnerable patients.
- When should I see a doctor for Candida parapsilosis symptoms?
Seek medical attention if you experience persistent fever, severe skin infections, or signs of sepsis.
- What is the long-term outlook for Candida parapsilosis infections?
With early diagnosis and appropriate treatment, most individuals can recover fully, although those with underlying health issues may require ongoing management.
When to See a Doctor
Seek immediate medical attention if you experience:
- Persistent fever that does not respond to treatment.
- Severe skin infections that worsen or do not improve.
- Symptoms of sepsis, such as confusion, rapid heart rate, or difficulty breathing.
Conclusion & Disclaimer
Candida parapsilosis is a significant opportunistic pathogen that can lead to serious infections, particularly in vulnerable populations. Understanding its causes, symptoms, and treatment options is essential for effective management and prevention. If you suspect an infection or have concerns about your health, consult a healthcare professional for personalized advice.
Disclaimer: This article is for informational purposes only and does not replace professional medical advice. Always consult a healthcare provider for medical concerns or questions regarding your health.


 Best Hospital Near me Chennai
Best Hospital Near me Chennai

